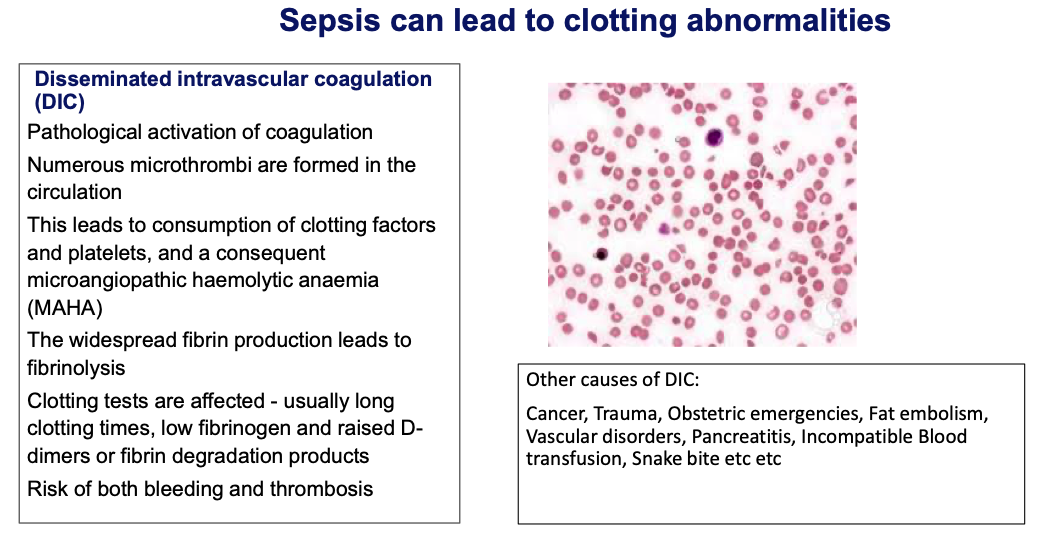

What is the definition of screening?
Trying to find people at risk of a disease that are otherwise healthy

What is the difference between primary, secondary and tertiary prevention and give some examples of screening programmes that are aiming to achieve each?
Primary: cervical smear, antenatal, genetic, Q risk
Secondary:
Tertiary: Diabetic retinopathy screening, diabetic foot

What are the different populations that can be used for screening?
- Mass e.g NIPE
- Selective e.g sickle cell
What are the advantages of screening?
- Reassurance
- Reduce morbidity and mortality

What are the disadvantages of screening?
- False negatives and false positives
- Inverse care law
- Expensive
- Overtreatment
- Lead and length time bias

What conditions does a screening programme need to fulfil to be treatable?
Disease, Test, Treatment, Programme, Implementation
Disease
- Must be serious
- Must be treatable
- Must have known disease progression
- All primary prevention strategies should have been implemented
Test
- Simple and safe
- Should be acceptable to target population
- Clear diagnostic investigation
- Sensitivity and specificity must be known
Treatment
- Should be beneficial to have early treatment
- Must have treatment available
What is sensitivity and how do you work it out?
Low false negatives
True +ve/No with disease

What is specificity and how do you work it out?
Low false positives
True negatives / No without disease

What is positive and negative predictive value?
Higher prevalence higher PPV
When patient with high risk result asks the likelihood of them actually having the disease

What is the difference between lead and length time bias?

Lead: early detection confused with increased survival
Length: screening picks up cancers with long latency period so these naturally have better survival

What are the five national screening programmes?
- Bowel cancer
- Antenatal
- Cervical cancer
- AAA
- Breast cancer
- Diabetic retinopathy and foot disease
How much screening is done antenatally?

How much screening is done neonatally?

What is infant mortality rate?

Why has infant mortality improved overtime?

- Less crowding
- Vaccination
- Sanitation
- Nutrition

Why did neonatal deaths improve in 1990’s?
Back to Sleep programme
What is the biggest risk factor with neonatal deaths?
Low birth weight

How can we prevent perinatal mortality worldwide?

What are some causes of maternal death?
- SUDEP
- Underlying cardiac issues
- VTE
- Mental health
- Post partum haemorraghe
What makes up an FBC?
Have to ask for reticulocytes as an add on

What is included in a basic clotting screen?
Always needs to do platelet count with it so do FBC as well

What questions do you need to ask yourself once you know somebody is anaemic?
- Reticulocyte count
- MCV
- Blood film

What are some causes of DIC?
Sepsis
What are some causes of DIC in pregnancy?























